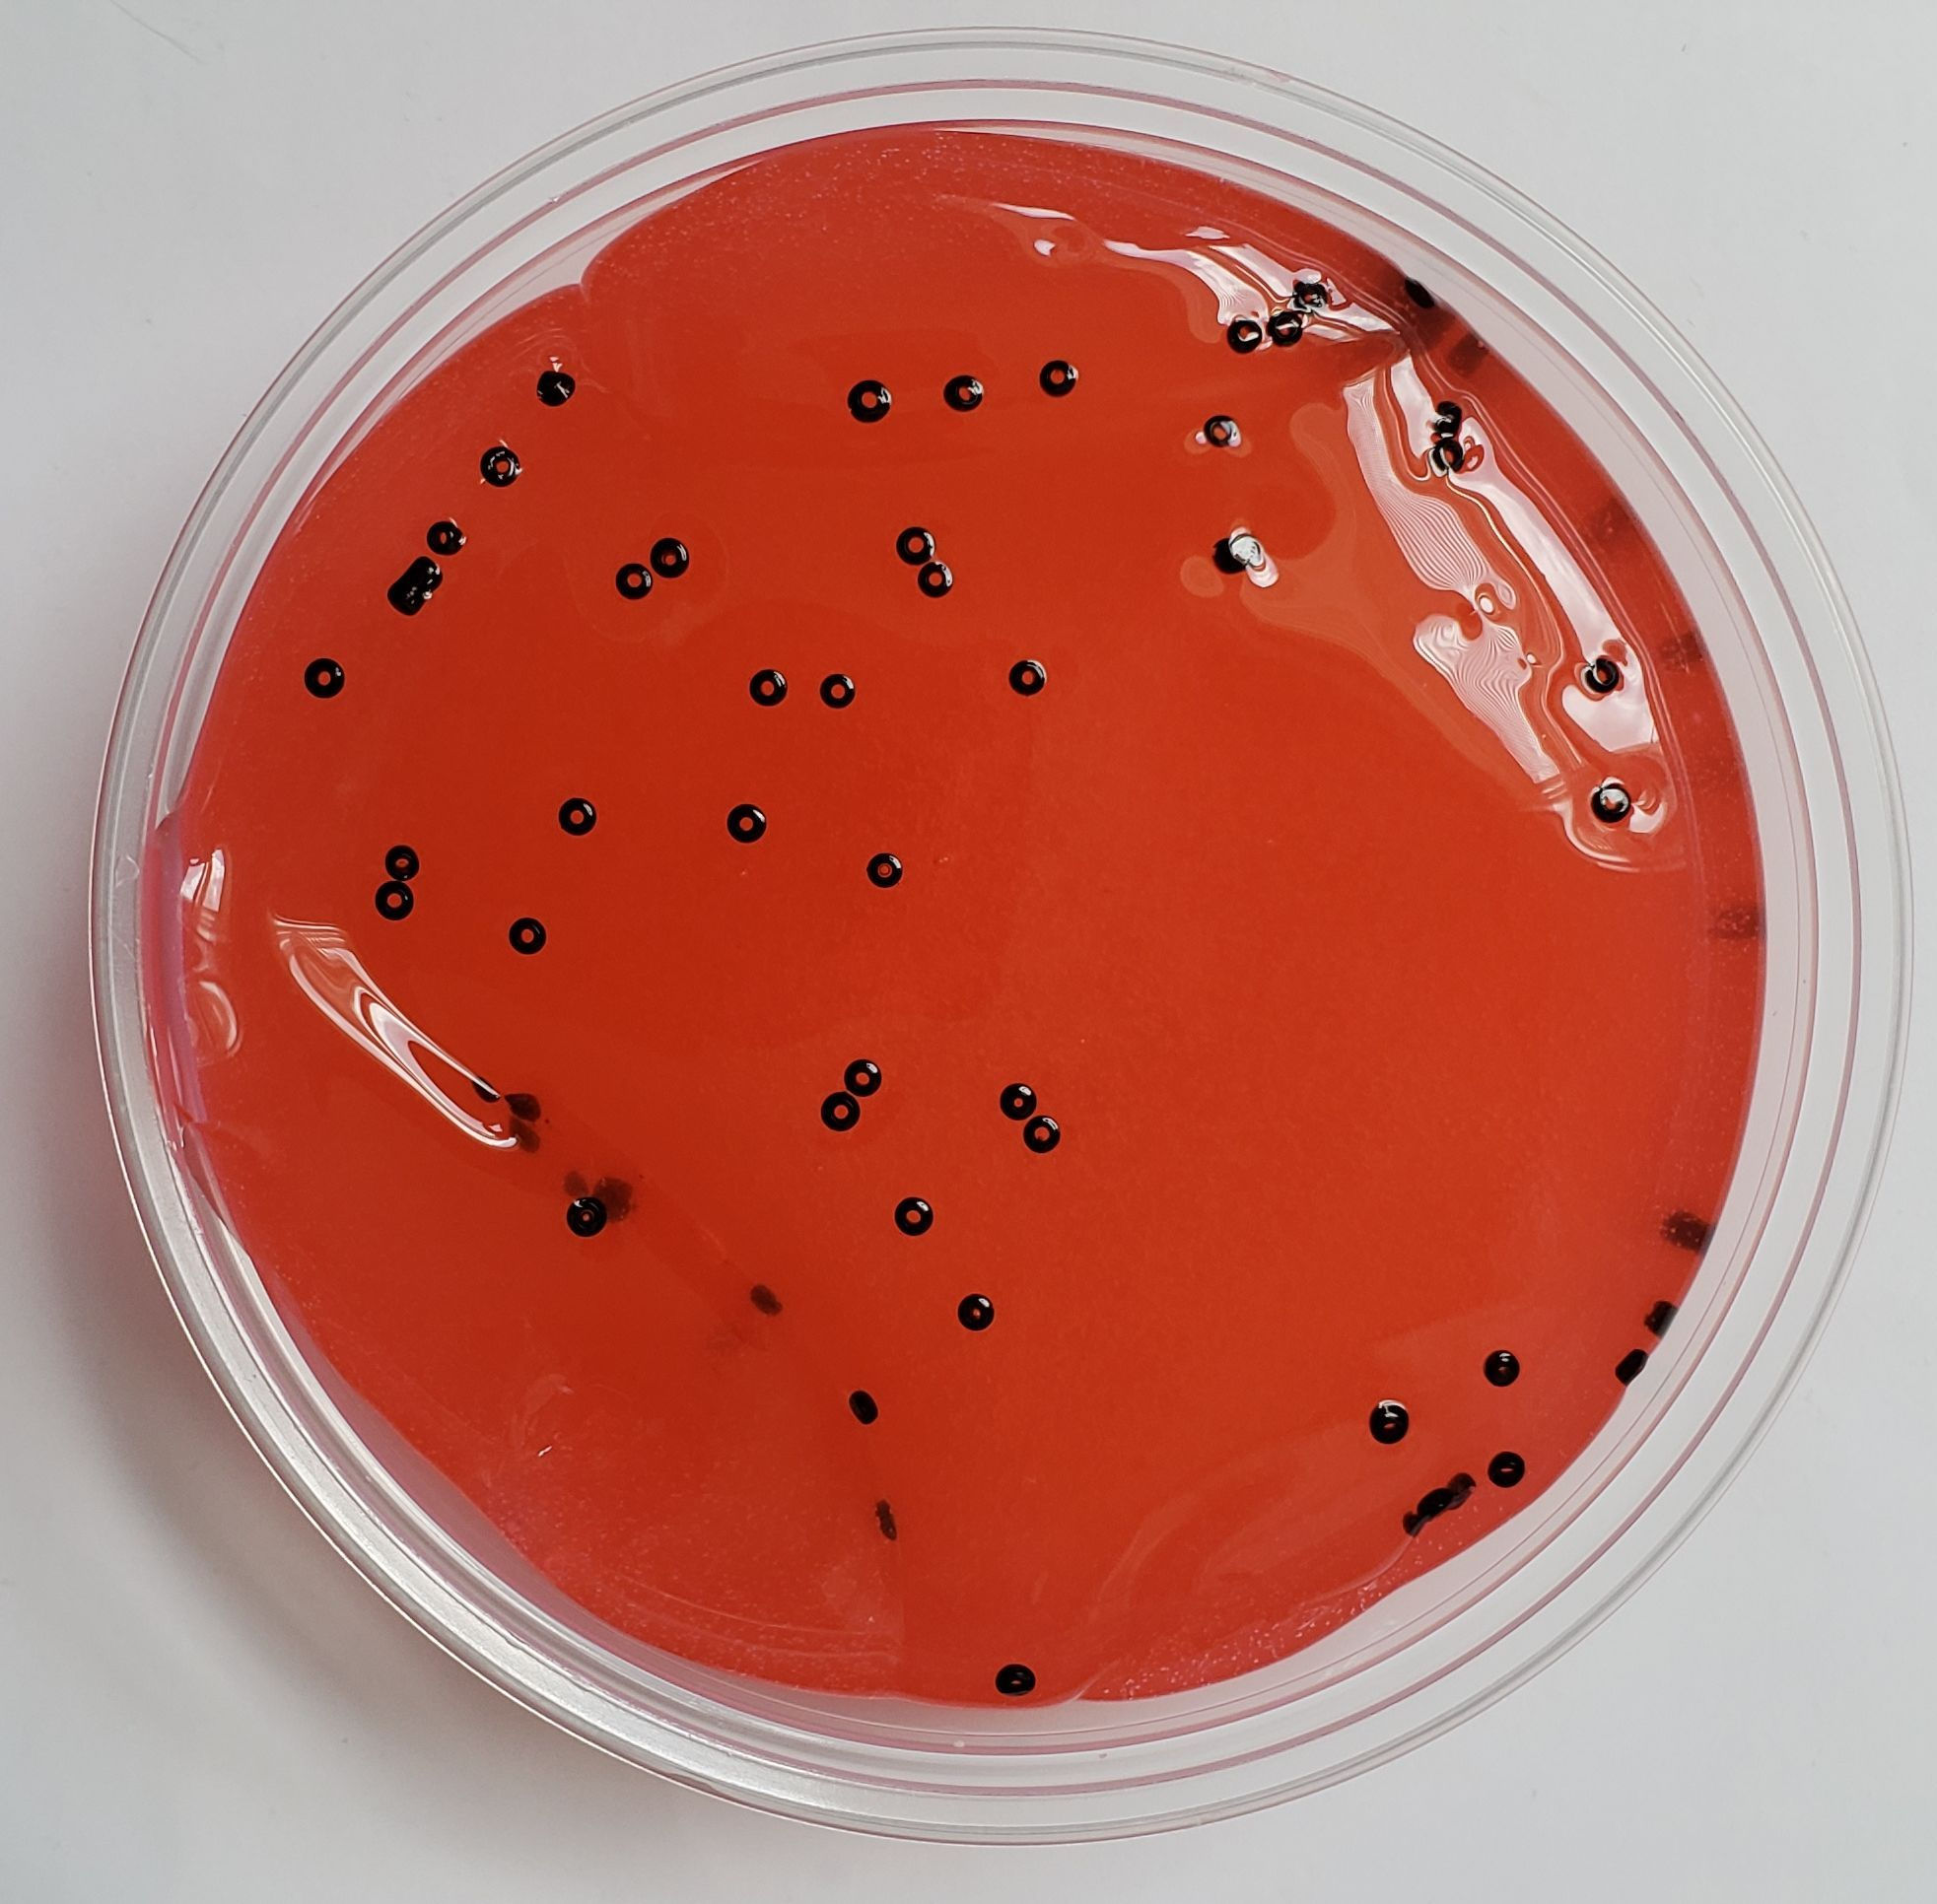
Dragonfruit

So shiny and clicky, smells citrusy. Mixed scents with beads.
Dragonfruit
$4.00Price
Our slimes are made to order and mailed out fresh; for that reason no returns are allowed and all sales are final. If poof of shipping damage is given we will consider replacing your item. Instructions will be provided for proper care so that your slime may last longer.